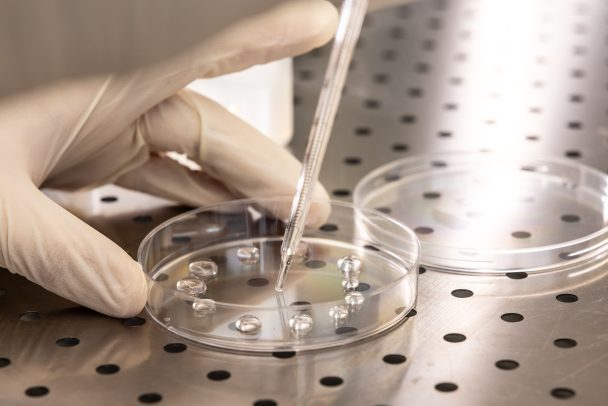
laboratorio analisi acque

Fiora, studenti in visita al laboratorio analisi
Per la classe II dell’Istituto tecnico tecnologico “B. Lotti” di Massa Marittima una giornata alla scoperta di una protagonista essenziale della vita di ciascuno di noi: la risorsa idrica Acqua e futuro, un binomio sempre più forte che vede protagoniste le nuove generazioni. Gli studenti dell’istituto “Bernardino Lotti” di Massa Marittima si sono recati nei…